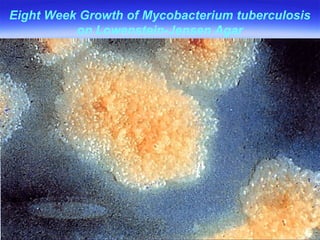
Eight Week Growth of Mycobacterium tuberculosis on Lowenstein-Jensen Agar

The document discusses Mycobacterium tuberculosis, the bacteria that causes tuberculosis. It describes the bacteria's morphology, staining properties, growth characteristics, and pathogenesis. It also covers the transmission and progression of tuberculosis infection, from primary infection to potential extrapulmonary sites. Granuloma formation and caseation necrosis are key aspects of the immune response and typical disease progression.